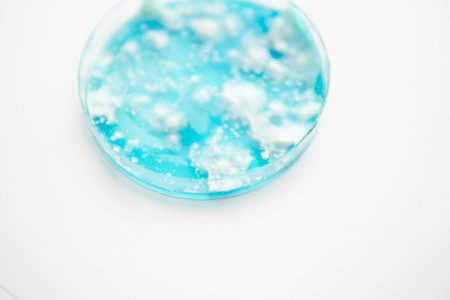
Psilocybin mushroom. Magic shroom in hand. Dry Psilocybe cubensis. energy micro dosing. Medicines physical. Psychedelic microdosing.の写真素材

写真素材 - Psilocybin mushroom. Magic shroom in hand. Dry Psilocybe cubensis. energy micro dosing. Medicines physical. Psychedelic microdosing.
作品情報
Psilocybin mushroom. Magic shroom in hand. Dry Psilocybe cubensis. energy micro dosing. Medicines physical. Psychedelic microdosing.
- ID:161096005
- 作品種別:写真
- 作者名:Dmitry Tishchenko
キーワード
- biology
- consciousness
- cubensis
- drug
- drugs
- dry
- ecology
- forest
- fungi
- fungus
- group
- growing
- growth
- hallucinogen
- hallucinogenic
- illegal
- isolated
- macro
- magic
- medical
- medicine
- mushroom
- mushrooms
- mycology
- mystery
- natural
- nature
- psilocin
- psilocybe
- psilocybe cubensis
- psilocybin
- psychedelic
- psychoactive
- psychotherapy
- recreational
- shrooms
- substance
- therapy
類似作品
Forest mushroom...
Fly agaric clos...
Psilocybin mush...
Psilocybin mush...
Medical researc...
effect of magic...
Scientific rese...
Fresh organic f...
A delicate mush...
Poisonous fores...
psilocybin mush...
A single mushro...
A single, vibra...
A vibrant close...
Mushroom on wat...
Dreamlike image...
Dry psilocybin ...
cultivation of ...
the benefits of...
Group of small,...
psilocybe semil...
Two dehydrated ...
Medical researc...
cultivation of ...
Many mushrooms ...
The Mexican mag...
Group of mushro...
Forest mushroom...
A lone mushroom...
growing psilocy...
Macro shot of a...
Woodland harves...
A group of hall...
Dry psilocybin ...
close-up of mus...
Macro photo of ...
Macro shot of a...
Psilocybe Cuben...
A mushroom sitt...
Psilocybin mush...
Delicate White ...
Scientific rese...
A stunning clos...
Dry psilocybin ...
growing psilocy...
The Mexican mag...
The Mexican mag...
Psilocybin mush...
psilocybin mush...